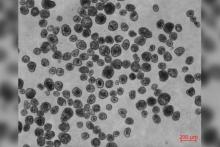
ساخت ربات‌های زنده از سلول‌های انسانی

ساخت رباتهای زنده از سلولهای انسانی
به گزارش سیتنا به نقل از ایندیپدنت، تیمی از دانشگاه تافتس و موسسه ویس دانشگاه هاروارد، نام رباتهای زنده را آنتروبات گذاشتهاند. این پژوهش بر اساس کار قبلی تعدادی از دانشمندانی انجام شده است که پیشازاین، نخستین رباتهای زنده یا زینوباتها را از سلولهای بنیادی جنین قورباغه پنجهدار آفریقایی ساخته بودند.
مایکل لوین، نویسنده این مقاله و استاد زیستشناسی دانشگاه تافتس، با اشاره به بحثهای درگرفته پیرامون اینکه آیا آنترباتها ماشین محسوب میشوند یا جانور زنده، میگوید که این چیزها خیلی به ما کمک نمیکند و باید از آن فراتر برویم.
بر اساس این پژوهش که در مجله «ساینس ادونسز» منتشر شده است، این رباتهای چندسلولی که ابعاد آنها در اندازه یک تار موی انسان تا نوک یک مداد تیز است، به شکلی ساخته شدهاند که میتوانند اثر قابلتوجهی بر سلولهای دیگر داشته باشند. به گفته محققان، این کشف یک نقطه آغاز برای استفاده از رباتهای زیستی ساخته شده از سلولهای بیماران است تا با ترمیم بافتهای آسیبدیده، بیماریها را درمان کند.
این تحقیق برگرفته از تحقیقات قبلی آزمایشگاههای چند دانشمند رشته زیستشناسی از دانشگاههای تافتس و ورمونت است. آنها در گذشته رباتهای زیستی چندسلولی را از سلولهای جنین یک قورباغه درست کرده بودند که از قابلیتهای جالبی ازجمله جمعآوری مواد، ثبت اطلاعات، خودترمیمی در مواقع آسیبدیدگی برخوردار بود.
با این حال، دانشمندان در جریان تحقیقات پیشین نمیدانستند که آیا امکان ساخت رباتهای زیستی از سلولهای گونههای دیگر وجود دارد یا نه.
اما اینک محققان دانشگاه تافتس و موسسه ویس دانشگاه هاروارد با استفاده از پژوهشهای پیشین دریافتند که میتوان رباتهای اینچنینی را از سلولهای انسان نیز بدون هیچگونه تغییر ژنتیکی ساخت. رباتهایی که به گفته آنها تواناییهایی فراتر از زینوباتها دارند.
به گفته دانشمندان، این آنترباتها که از سلولهای ریه انسان ساخته شدهاند، خودبهخود حرکت میکنند، با یکدیگر همکاری میکنند و درعینحال میتوانند نورونهای آسیبدیده را ترمیم کنند.
مایکل لوین، مدیر مرکز اکتشافات آلن در تافتس، در آن زمان پس از ساخت زینوباتها گفته بود: «برخی افراد میگفتند که زینوباتها ارگانیسم (زنده) نیستند، چون تولیدمثل نمیکنند. اما آنها اکنون تولیدمثل هم میکنند.»
نسل اول این رباتها با استفاده از سلولهای پرزدار محیط جنین قورباغه ساخته شده بود و به گفته محققان، رباتها میتوانستند تا پنج نسل به همانندسازی ادامه دهند.
دانشمندان میگویند آنترباتهای ساختهشده شکل ظاهری یکسانی ندارند و به روشهای مختلفی نیز حرکت میکنند. به گفته آنها، این آنترباتها تا ۶۰ روز در شرایط آزمایشگاهی زنده ماندهاند.
لوین و همکارانش میگویند که آزمایشهای انجامشده در این مطالعه جدید هنوز در مراحل اولیه است.
او میگوید: «هدف این است که بفهمیم آیا آنترباتها میتوانند کاربردهای پزشکی داشته باشند یا خیر.»
دانشمندان برای اینکه ببینند آیا کاربردهای درمانی و پزشکی برای این رباتها وجود دارد، این موضوع را بررسی کردند که آیا آنترباتها اساسا میتوانند روی نورونهای انسانی رشد کنند یا خیر.
درنهایت، آنها مشاهده کردند که آنترباتها در ناحیه آسیبدیده نورونها رشد میکنند. بااینوجود، دانشمندان میگویند که هنوز سازوکار این روش را درک نکردهاند.
فالک تاوبر، پژوهشگر دانشگاه فرایبورگ آلمان که خود در انجام این تحقیق مشارکت نداشته است، میگوید این مطالعه، مبنایی را برای تلاشهای آتی بهمنظور استفاده از رباتهای زیستی برای عملکردهای مختلف و همچنین ساخت آنها در اشکال مختلف فراهم میکند. او میگوید آنترباتها با توجه به اینکه از سلولهای خود بیمار گرفته میشوند، «رفتار شگفتانگیزی» از خود نشان میدهند.
لوین نیز در ادامه میافزاید که تصور نمیکند آنترباتها نگرانیهای اخلاقی یا ایمنی درپی داشته باشند. به گفته او، آنها از جنین انسان ساخته نشدهاند، و در زمره تحقیقات جنینی که بهشدت محدود شدهاند قرار نمیگیرند. آنها محیط بسیار محدودی دارند که در آن زندگی میکنند، بنابراین هیچ امکانی برای آنها وجود ندارد که به نحوی از آزمایشگاه بیرون بروند یا در خارج از آزمایشگاه زندگی کنند. به گفته لوین، آنتروباتها طول عمر طبیعی دارند و ازاینرو پس از چند هفته، بهکلی تجزیه میشوند.
انتهای پیام
